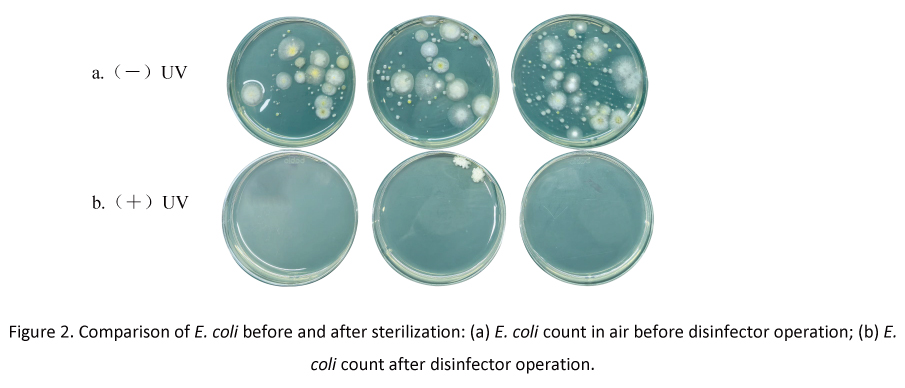
4
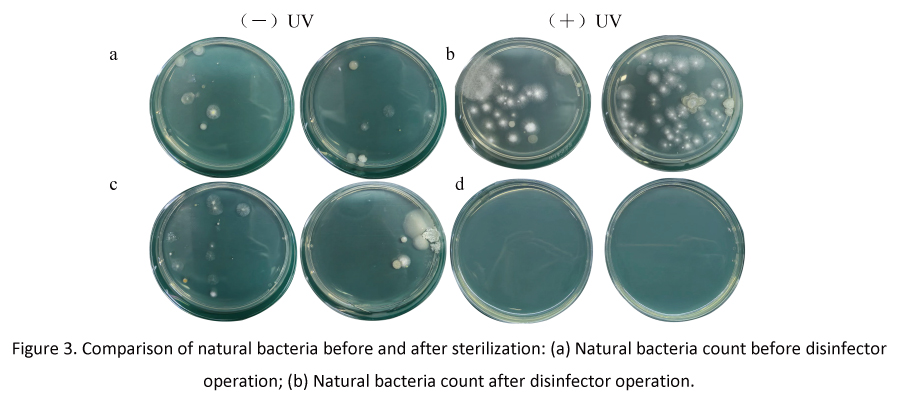
6

A Study on the Performance of an Oral Disinfector Based on UV-C LED Disinfection Technology
Main text
Figures
Tables
References
LED UV-C LED technology has garnered significant attention as a cutting-edge solution for controlling the spread of infectious and epidemic diseases. This study innovatively integrates UV-C LED technology into an oral disinfector, developing an air disinfection system based on circulating air adsorption. The system effectively captures droplets and aerosols generated during oral diagnosis and treatment, achieving efficient microbial inactivation through an integrated UV-C LED sterilization module. Non-pathogenic Escherichia coli and natural environmental bacteria were selected as test subjects to simulate real-world oral treatment scenarios and evaluate sterilization efficiency. Results show that the disinfector achieves a sterilization rate of 97.22% for E. coli and 96.24% for natural bacteria, demonstrating excellent air microbial disinfection efficacy. Additionally, to ensure safe operation, irradiance intensity was measured at three key positions (left, middle, right) around the disinfector, confirming no UV leakage risk during operation. This study represents a systematic exploration of UV-C LED disinfection technology in simulated oral clinical settings, providing critical data support for bioaerosol inactivation and offering theoretical and practical foundations for advancing infection control technologies in oral healthcare environments.
Keywords
With rising living standards and growing health awareness, oral health has become a focal point of public concern, leading to a significant increase in dental visits. However, oral treatment processes are unique, as high-speed handpieces, ultrasonic devices, and other tools generate aerosols by mixing saliva, blood, and other substances with air droplets [1-3]. Smaller aerosols can remain suspended in the air for extended periods, eventually settling on surfaces or being inhaled, while larger droplets typically follow ballistic trajectories, detectable 2–4 meters from the treatment site but decreasing with distance from the source [4-8]. Current hospital air disinfection methods primarily focus on overall room sterilization. While air purifiers effectively reduce some airborne particles and microbes in large spaces, they are less effective against high-concentration, close-range droplets produced in dental settings [9-11]. In busy oral clinics, where doctors and patients are in close proximity, droplets can rapidly spread to healthcare workers and the surrounding environment, and air purifiers often fail to address these promptly, resulting in persistent infection risks.
Existing air purification devices lack designs tailored for oral droplets, unable to achieve targeted collection and efficient disinfection, thus failing to fundamentally address droplet transmission in dental treatments. Developing an oral disinfector capable of extracting and disinfecting air from the upper oral cavity is of significant importance.
MASSPHOTON’s independently developed oral disinfector integrates aerodynamic principles with mercury-free UV-C LED disinfection technology for the first time [13-17]. UV-C LEDs, an emerging disinfection technology, emit 260–280 nm ultraviolet light to induce dimerization in DNA and RNA bases (particularly thymine/uracil), rendering pathogens unable to replicate [12]. Unlike traditional methods that treat ambient air broadly, MASSPHOTON’s disinfector extracts droplets at their source, preventing their spread within the clinic and significantly reducing cross-infection risks between healthcare providers and patients.

3.1 UV Irradiance Intensity
UV irradiance intensity, defined as the UV radiation power received per unit area, directly impacts sterilization efficacy. Testing revealed that the UV-C LED lamps in the disinfector, after a 5-minute warm-up, deliver an irradiance intensity of 24,368.2–27,134.5 µW/cm² at a vertical distance of 2 cm directly below the lamp, with an average of 25,956.0 µW/cm² (Table 1).

Most UV wavelengths are harmful to human tissues, with UV-A, UV-B, and UV-C known to cause varying degrees of skin and eye damage [19-21]. To ensure safety, UV exposure must be minimized or eliminated. Researchers measured UV irradiance at the left, middle, and right diagonal positions around the disinfector, 30 cm vertically from the device, after reaching stable operation. Each measurement was repeated three times for accuracy and reliability.
Results show UV irradiance values below 1 µW/cm² at all positions (Table 2), well below safety thresholds, confirming that the disinfector poses no UV leakage risk and ensures safe coexistence with users.
[Table 2. UV Leakage Test.]

During oral treatments, high-speed handpieces generate aerosols from saliva, blood, and other substances, mixing with air droplets and remaining suspended in the clinical environment. To evaluate the disinfector’s efficacy against common environmental microbes, professional microbial sampling and culturing methods were employed.
Non-pathogenic E. coli (8099) was used as the test indicator. Before operating the disinfector, an E. coli suspension was sprayed uniformly at the suction vent. To simulate real-world conditions, a handheld sprayer was used at the outlet for intermittent spraying (10 seconds). After stable operation, a six-stage sieve air impactor collected E. coli colony counts at the suction and outlet vents. Samples were incubated upside-down at 36 ± 0.5°C for 48 hours, followed by colony counting.
[Table 3. E. coli Bactericidal Rate Test.]


3.4 Bactericidal efficacy assessment of microbial contamination
Given that the device’s air intake vent faces upward while the exhaust vent is oriented downward, variations in airflow and the distribution of airborne microorganisms (naturally occurring microorganisms in the air, primarily including bacteria, fungi, and actinomycetes) may persist even within the same room. This could potentially influence sterilization efficacy.
To ensure the experimental results accurately reflect the actual germicidal performance of the oral disinfecting device, researchers collected air samples at both the intake and exhaust vents before and after device activation.
The collected petri dishes were incubated in a constant-temperature incubator at 36 ± 0.5℃. After incubation, microbial colony growth on the dishes was observed and quantified.
[Table 4. Natural Bacteria Sterilization Rate Test]


The MASSPHOTON oral disinfector innovatively combines UV-C LEDs, high-reflectivity materials, and efficient filtration. Compared to conventional UV lamps, UV-C LEDs offer advantages such as mercury-free operation, no warm-up time, long lifespan, and compact size [22]. Testing in simulated scenarios demonstrated sterilization rates of 97.22% for E. coli and 96.24% for natural bacteria, indicating strong disinfection capabilities. No UV radiation leakage or ozone production was detected, ensuring user safety. While the device has not yet been tested in clinical hospital settings, future studies will evaluate its performance in real dental clinics to provide a safer treatment environment and further scientific support for the field.
[1]. Nunayon, S.S., et al., Evaluating the efficacy of a rotating upper-room UVC-LED irradiation device in inactivating aerosolized Escherichia coli under different disinfection ranges, air mixing, and irradiation conditions. Journal of hazardous materials, 2022. 440(Oct.15): p. 1-12.
[2]. Allison JR, E.D.B.C., The effect of high-speed dental handpiece coolant delivery and design on aerosol and droplet production. J Dent, 2021(112:103746. doi: 10.1016/j.jdent.2021.103746. Epub 2021 Jul 13. PMID: 34265364.).
[3]. B, P., Aerosol and bioaerosol particles in a dental office. Environ Res, 2014(134:405-9. doi: 10.1016/j.envres.2014.06.027. Epub 2014 Sep 22. PMID: 25218707.).
[4]. J., S., Dental bioaerosol as an occupational hazard in a dentist's workplace. Ann Agric Environ Med, 2007(14(2):203-7. PMID: 18247451.).
[5]. Peng X, X.X.L.Y., Transmission routes of 2019-nCoV and controls in dental practice. Int J Oral Sci, 2020(12(1):9. doi: 10.1038/s41368-020-0075-9. PMID: 32127517; PMCID: PMC7054527.).
[6]. Shahdad S, P.T.H.A., The efficacy of an extraoral scavenging device on reduction of splatter contamination during dental aerosol generating procedures: an exploratory study. Br Dent J. 2020 Sep 11:1 – 10. doi: 10.1038/s41415-020-2112-7. Epub ahead of print. Erratum in: Br Dent J., 2020(doi: 10.1038/s41415-020-2288-x. PMID: 32918060; PMCID: PMC7484927.).
[7]. Ionescu AC, C.M.F.J., Topographic aspects of airborne contamination caused by the use of dental handpieces in the operative environment. J Am Dent Assoc, 2020(151(9):660-667. doi: 10.1016/j.adaj.2020.06.002. Epub 2020 Jul 1. PMID: 32854868; PMCID: PMC7328555.).
[8]. Takanabe Y, M.Y.K.J., Dispersion of Aerosols Generated during Dental Therapy. Int J Environ Res Public Health, 2021(18(21):11279. doi: 10.3390/ijerph182111279. PMID: 34769795; PMCID: PMC8583477.).
[9]. Rutala WA, W.D., Disinfection and Sterilization in Health Care Facilities: An Overview and Current Issues. Infect Dis Clin North Am, 2021(35(3):575-607. doi: 10.1016/j.idc.2021.04.004. PMID: 34362535.).
[10]. Zhang B, L.L.Y.X., Analysis of Air Purification Methods in Operating Rooms of Chinese Hospitals. Biomed Res Int, 2020(2020:8278943. doi: 10.1155/2020/8278943. PMID: 32076617; PMCID: PMC7016480.).
[11]. Hakim H, G.C.T.L., Effect of a shielded continuous ultraviolet-C air disinfection device on reduction of air and surface microbial contamination in a pediatric oncology outpatient care unit. Am J Infect Control., 2019(47(10):1248-1254. doi: 10.1016/j.ajic.2019.03.026. Epub 2019 May 1. PMID: 31053377.).
[12]. Beck SE, R.H.B.L., Evaluating UVC-LED disinfection performance and investigating potential dual-wavelength synergy. Water Res, 2017(109:207-216. doi: 10.1016/j.watres.2016.11.024. Epub 2016 Nov 7. PMID: 27889622; PMCID: PMC6145099.).
[13]. Zhang H, L.A., Evaluation of Single-Pass Disinfection Performance of Far-UVC Light on Airborne Microorganisms in Duct Flows. Environ Sci Technol, 2022(56(24):17849-17857. doi: 10.1021/acs.est.2c04861. Epub 2022 Dec 5. PMID: 36469399.).
[14]. Górny RL, G.M.P.A., Effectiveness of UV-C radiation in inactivation of microorganisms on materials with different surface structures. Ann Agric Environ Med, 2024(31(2):287-293. doi: 10.26444/aaem/189695. Epub 2024 Jun 25. PMID: 38940114.).
[15]. Corson E, P.B.P.A., Hepatitis A virus inactivation in phosphate buffered saline, apple juice and coconut water by 254 nm and 279 nm ultraviolet light systems. Food Microbiol, 2025(129:104756. doi: 10.1016/j.fm.2025.104756. Epub 2025 Feb 20. PMID: 40086994).
[16]. Labadie, M., et al., Cell density and extracellular matrix composition mitigate bacterial biofilm sensitivity to UVC-LED irradiation. Applied Microbiology and Biotechnology, 2024. 108(1).
[17]. Bhardwaj SK, S.H.D.A., UVC-based photoinactivation as an efficient tool to control the transmission of coronaviruses. Sci Total Environ, 2021: p. 792:148548.
[18]. Rocha-Melogno L, X.J.D.M., Experimental evaluation of a full-scale in-duct UV germicidal irradiation system for bioaerosols inactivation. Sci Total Environ, 2024(947:174432. doi: 10.1016/j.scitotenv.2024.174432. Epub 2024 Jul 2. PMID: 38960181.).
[19]. Ishida, K., et al., Free-Radical Scavenger NSP-116 Protects the Corneal Epithelium against UV-A and Blue LED Light Exposure. Biological & pharmaceutical bulletin, 2021. 44(7): p. 937-946.
[20]. Sathid Aimjongjun, M.S.N.L., Silk lutein extract and its combination with vitamin E reduce UVB-mediated oxidative damage to retinal pigment epithelial cells. Journal of Photochemistry and Photobiology B: Biology, 2013. Pages 34-41(Volume 124).
[21]. DJ, B., Far-UVC Light at 222 nm is Showing Significant Potential to Safely and Efficiently Inactivate Airborne Pathogens in Occupied Indoor Locations. Photochem Photobiol, 2023(99(3):1047-1050. doi: 10.1111/php.13739. Epub 2022 Nov 21. PMID: 36330967.).
[22]. Alonzo A. Gabriel, M.L.P.B., Elimination of Salmonella enterica on common stainless steel food contact surfaces using UV-C and atmospheric pressure plasma jet. Food Control, 2018. 86: p. 90-100.

Get in Touch
Recent Posts
-
 MASSPHOTON will participate in WATERTECH CHINA 2026 (June 9–11, Shanghai), showcasing advanced UVC LED water disinfection modules for residential, commercial, and industrial applications. With 5-log (99.999%) disinfection performance, mercury-free operation, and high integration flexibility, the solutions support sustainable and smart water treatment. Visitors are invited to explore innovations at Booth 2.1H-413.
MASSPHOTON will participate in WATERTECH CHINA 2026 (June 9–11, Shanghai), showcasing advanced UVC LED water disinfection modules for residential, commercial, and industrial applications. With 5-log (99.999%) disinfection performance, mercury-free operation, and high integration flexibility, the solutions support sustainable and smart water treatment. Visitors are invited to explore innovations at Booth 2.1H-413. -
 This study examines how temperature influences UV-C LED performance and water disinfection efficiency. Higher temperatures reduce output power, accelerate degradation, and lead to insufficient disinfection dose. Effective thermal management is essential to ensure stable performance and reliable sterilization.
This study examines how temperature influences UV-C LED performance and water disinfection efficiency. Higher temperatures reduce output power, accelerate degradation, and lead to insufficient disinfection dose. Effective thermal management is essential to ensure stable performance and reliable sterilization.








